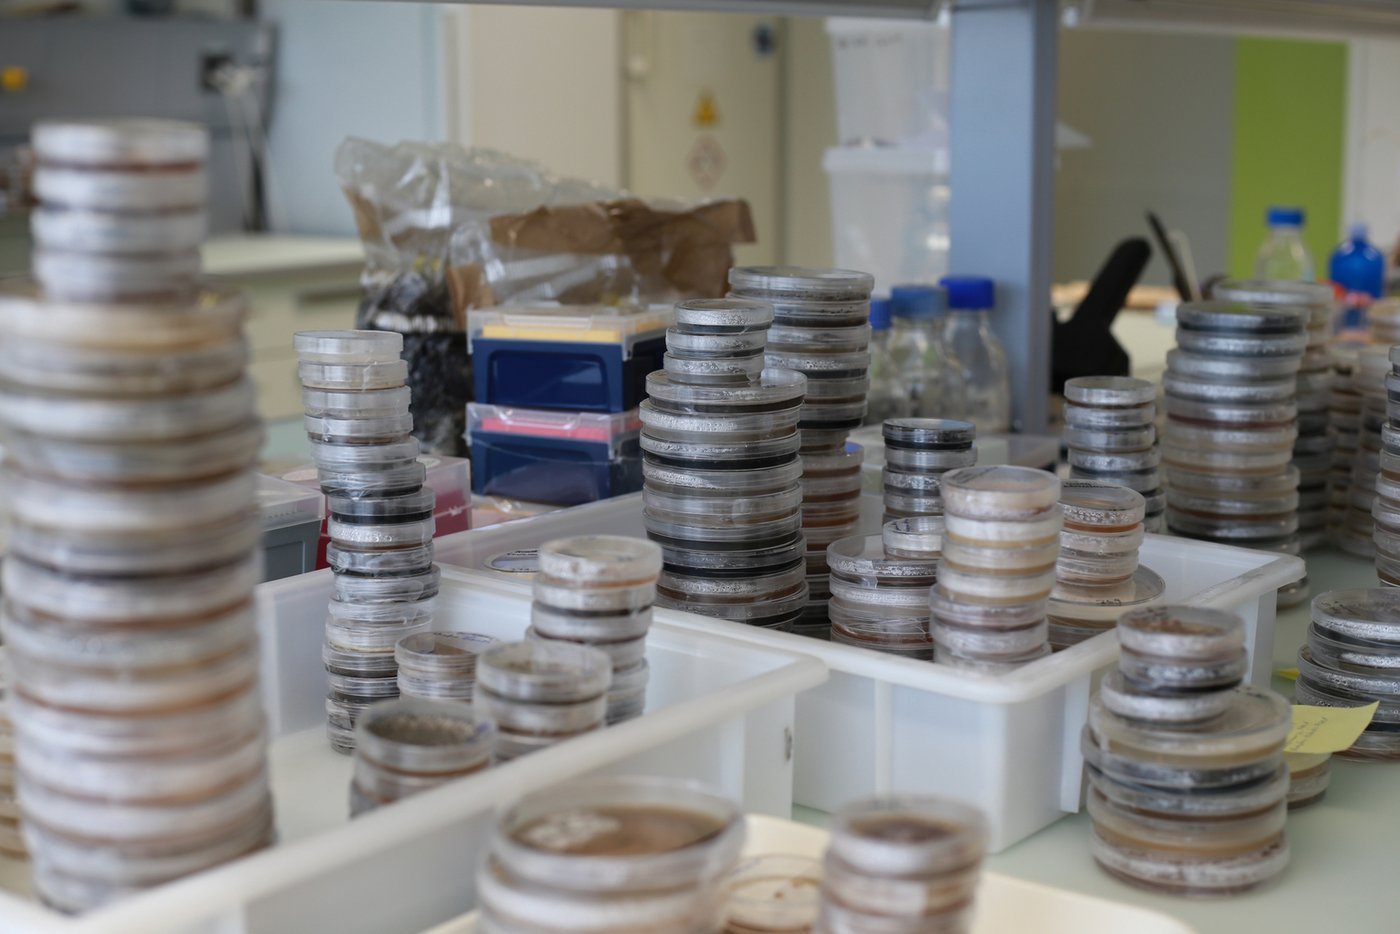
Die Schimmelsammlung in Changins ist vielfältig. Schimmelproben von Avocado, Äpfel, Karotten etc. werden kultiviert und können für die Forschung verwendet werden.

Wer mit Heisshunger den Kühlschrank öffnet und feststellen muss, dass die am Vortag gekauften Erdbeeren bereits anfangen zu schimmeln, ist nicht nur enttäuscht, sondern produziert auch Food Waste (siehe Infobox). Diese Situation kennt Olga Dubey nur zu gut. Die Biologin entdeckte bei ihrer Recherche während des Studiums, dass ein Pflanzenmolekül das Verfaulen eines Apfels verhindern kann, und witterte grosses Potential. Also untersuchte sie im Rahmen ihrer Doktorarbeit die fungizide Wirkung des Moleküls und liess ihre Entdeckung patentieren.
Von der Wissenschaftlerin zur Unternehmerin
Nach ihrer Doktorarbeit besuchte sie eine Reihe von Unternehmens-Kursen und gründete 2018 gemeinsam mit ihrem Ehemann Sylvain Dubey das Unternehmen Agrosustain. Das 9-köpfige Team des Start-ups entwickelt Fungizide auf Basis eines Moleküls aus der Pflanzenfamilie der Kreuzblütler. Diese sind biologisch abbaubar und halten trotzdem Krankheitserreger und Schädlinge fern. "Ziel ist es, nur den Pilz zu bekämpfen, der der Pflanze Schaden zufügt und die Umwelt nicht zu belasten", erklärt Sylvain Dubey.
Food Waste in der Schweiz
Gemäss Bundesamt für Umwelt (BAFU) würde die Hälfte der schweizweit landwirtschaftlich genutzten Fläche benötigt, um die Lebensmittel anzubauen, die in der Schweiz jährlich entlang der gesamten Wertschöpfungskette weggeworfenen werden. Nebst den enormen Kosten, die entstehen, wird die Umwelt belastet: ein Viertel der Umweltbelastung der Ernährung der Schweiz sind gemäss BAFU auf vermeidbare Lebensmittelverluste zurückzuführen.
Gebündeltes Wissen im Haus
Nicht zufällig hat das junge Unternehmen seinen Sitz an der Forschungsanstalt für Landwirtschaft Agroscope in Changins. "Wir profitieren enorm vom Wissen hier im Haus", sagt Dubey. Und das Team nutzt die Infrastruktur mit Laboratorien und Gewächshäusern zu Versuchszwecken. Dubey ist froh über den Austausch mit Agroscope-Forschenden, die im selben Haus eine grosse Mykothek betreiben; eine Datenbank für die ganze Vielfalt der Pilz- und Schimmelstämme, die in der Schweiz vorkommen.
Etwa die Hälfte des Teams von Agrosustain widmet sich im Labor täglich den Versuchen. Säuberlich organisiert stehen da Boxen mit exotischen und hiesigen Früchten, die in Plastiksäcke verpackt sind und bereits Schimmel ansetzen. "Wir empfehlen unseren Kunden, uns Obst zu senden, das sie gemäss ihrem üblichen Verfahren behandeln. So können wir herausfinden, welche Pestizide sie zukünftig nicht mehr einsetzen sollen, weil sie offensichtlich nichts bringen", sagt Olga Dubey.
Plädieren für wissenschaftlich fundierten Pestizideinsatz
Sie wünscht sich einen wissenschaftlicheren Ansatz beim Pestizid-Einsatz. "Krankheiten auf dem Feld werden noch immer meistens rein optisch bestimmt, ohne eine Probe im Labor analysieren zu lassen. Wenn dann gegen den falschen Pilz oder das falsche Virus gespritzt wird, ergeben sich hohe wirtschaftliche und ökologische Kosten, die vermeidbar wären", erklärt Olga Dubey. Sie ergänzt, dass sich auf diese Weise leicht Resistenzen bilden könnten.
Schnelleres Testverfahren
Noch fokussiert sich Agrosustain auf Nacherntebehandlungen: "In dem Bereich gibt es bisher noch wenige Produkte. Ausserdem verläuft das Testverfahren viel schneller." Weil die Produkte zur Nacherntebehandlung nur in geschlossenen Bereichen appliziert werden, müssen weniger Toxikologie-Tests durchgeführt werden, erklärt Sylvain Dubey. Das Produkt lasse sich aber auch auf dem Feld anwenden, ein weiterer Trumpf, den das Start-up vorerst im Ärmel behält.
Früchte, Gemüse und Blumen profitieren davon
Das Hauptaugenmerk beim Anwendungsgebiet liegt momentan auf den Beeren, weil diese die höchsten Nachernteverluste aufweisen. Agrosustain will aber auch Lösungen bei Karotten und Kartoffeln bieten, die beide eine lange Lagerzeit haben, sowie Bananen, die eine lange Reisezeit hinter sich haben, wenn sie im Schweizer Detailhandel ankommen. Im Gewächshaus laufen zudem Versuche mit Blumen. Da das Produkt in Pulverform daherkommen wird, ist es für die Anwendung flexibel einsetzbar, sagt Sylvain Dubey: "Orangen können damit besprayt, Bananen oder Ananas in ein angereichertes Bad gedippt und Erdbeeren mit Dampf behandelt werden.".
International früher auf dem Markt
Noch laufen die Zulassungstests, 2022 soll ihr Produkt auf dem russischen Markt erhältlich sein. "Ein Jahr später dann in den USA und voraussichtlich noch ein Jahr später auch in Europa", sagt die Geschäftsführerin Olga Dubey. Auf die Frage, ob sie die wissenschaftliche Forschung denn nicht vermisse, lacht die junge Frau und winkt ab. "Ich habe die Firma ja gegründet, weil ich kein Post-Doc sein wollte. Ich habe immer an die Wichtigkeit der angewandten Forschung geglaubt, die erhebliche wirtschaftliche und ökologische Auswirkungen haben kann", sagt sie. Die Arbeit bei einem Start-up sei herausfordernd, deshalb war für sie von Anfang an klar, dass sie das Unternehmen nicht alleine gründen wollte. "An Tagen, an denen es nicht besonders gut läuft, bin ich froh, dass mein Team mich unterstützt wir zusammen Lösungen finden können."
Death Valley überstanden
Als das junge Unternehmen das erste Jahr dank finanzieller Unterstützung von Investoren und Subventionen von Kanton und Bund hinter sich gebracht hatte, galt es, die erarbeiteten Konzepte in Wirklichkeit umzusetzen und erneut Geld zu sammeln. Da war es vor allem die moralische Unterstützung von Agroscope-Expertinnen und -Experten im Haus, die dem Start-up die Brücke über das ominöse "Death Valley" baute. "Wir erhielten viele wertvolle Tipps, so konnten wir unzählige Fehler vermeiden und Zeit sparen", sagt Olga Dubey.
Während die Zulassungstests für ihre Produkte laufen, ruht sich das junge Team von Agrosustain nicht etwa aus, im Gegenteil. "Einerseits pflegen wir die Kundenbeziehung und sammeln Geld für weitere Investitionen, andererseits sind wir daran, unsere Produktpalette zu erweitern", so CEO Olga Dubey.